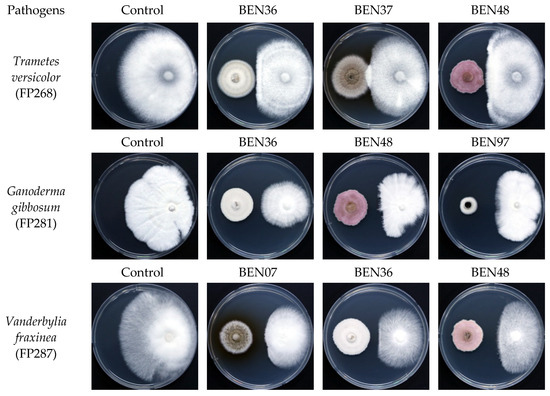
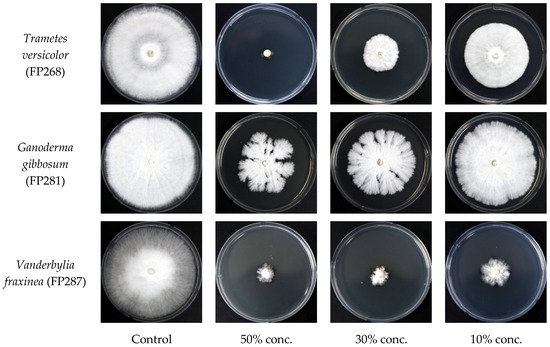

Abstract
Endophytic fungi play a vital role in protecting and promoting the growth of their host plants. The diversity of fungal endophytes has been documented across different host plant species and varies depending on factors such as the species of the host, ecological conditions, and the health status of the plant. We isolated endophytic fungi from Prunus yedoensis trees with different decay rates. A total of 31 species were isolated from decayed trees, while 33 species were obtained from healthy trees. The number of endophytic fungi exhibiting antifungal activities against wood decay fungi was higher in healthy trees, with 10 species showing activity compared to only 1 species from decayed trees. Endophytic fungus Fusarium acuminatum (BEN48) had the highest inhibition rates against Trametes versicolor, Ganoderma gibbosum, and Vanderbylia fraxinea. Heating conditions did not significantly affect the inhibitory ability of the culture filtrate from BEN48 on wood decay fungi. At 50% concentration, the inhibitory abilities of the culture filtrates against Trametes versicolor, Ganoderma gibbosum, and Vanderbylia fraxinea were 96.5%, 64.1%, and 92.7%, respectively. The inhibitory effects against Trametes versicolor decreased at concentrations of 30% and 10%, resulting in inhibition rates of 83.7% and 50.8%, respectively. For Ganoderma gibbosum, the inhibition rate reduced to 52.6% at 30% concentration and 24.5% at 10% concentration. For Vanderbylia fraxinea, there was no significant difference between the 30% and 10% concentrations, and the inhibition rates for both concentrations were high, measuring 89.9% and 88.8%, respectively. Hence, Fusarium acuminatum (BEN48) has promise as a biocontrol agent for managing wood decay fungi.
1. Introduction
Fungal endophytes can inhabit various plant tissues, exhibiting high species richness across host tree species [1,2,3]. Each tree species can host one or even several hundred endophytic fungal isolates [4]. Endophytic fungi are diverse in both coniferous and broad-leaved trees [3,5]. The diversity of endophytic fungi is greater in forest trees than in other plants [6]. However, the dominant species of fungal endophytes varies among different host trees and is influenced by geography, tree species, environmental conditions, tree genotypes, and tree age [3,6,7]. Additionally, the number of endophytic fungal isolates obtained can depend on the surface sterilization method used, the size of the tissue samples collected, and the types of culture media employed [8,9]. Endophytic fungi are an effective biocontrol agent and play an important role in controlling diseases in agriculture and forestry [10,11]. For example, Daldinia childiae and Alternaria alternata isolated from Quercus species showed antifungal activities against oak wilt disease caused by Raffaelea quercus-mongolicae [12]. This pathogen was also inhibited by the culture filtrate of endophytic fungus Nectria balsamea isolated from Pinus densiflora [12,13]. Several fungal endophytes can produce compounds that have antifungal properties and suppress plant pathogens [14]. Pestalachlorides A (C21H21Cl2NO5) and B (C20H18Cl2O5) were compounds produced by the endophytic fungus Pestalotiopsis adusta. These two compounds could inhibit popular plant pathogens Verticillium albo-atrum, Gibberella zeae, and Fusarium culmorum [15]. The endophytic fungus Chaetomium globosum and Phomopsis species isolated from Ginkgo biloba produced Cytosporones B and C and Chaetomugilins A and D, which exhibited antifungal activities against Candida albicans and Fusarium oxysporum [16].
P. yedoensis has been widely grown in several Northeast Asian countries, including South Korea [17,18,19,20]. This species is commonly cultivated in urban areas and produces beautiful blooms in the spring [17,21]. Research on tissue cultures of P. yedoensis and the effects of technical measures on the rooting and growth of transplanted cuttings has been conducted in South Korea [22,23,24]. Furthermore, the leaf extract from this tree demonstrated various biological activities, including antimicrobial properties, the crystallization of silver metal, and the removal of phosphate [25,26,27,28]. However, P. yedoensis trees have been observed to show symptoms of trunk decay caused by various white rot fungi, mainly including Ganoderma gibbosum, Trametes versicolor, and Vanderbylia fraxinea [29,30]. Several decayed trees may die while standing or could fall, posing risks in urban areas. Research on the control of these fungi is still limited in South Korea. The antifungal activity of actinomycete strains against brown rot fungi was evaluated through screening [31]. While the use of endophytic fungi for the biological control of phytopathogens has been explored for some pathogens, there has been no investigation into selecting endophytic fungal isolates from P. yedoensis trees that exhibit antifungal activity against these white rot fungi. Therefore, this study was conducted to isolate and select endophytic fungal isolates with antifungal activity in both dual culture and culture filtrate experiments and to evaluate the effects of different concentrations on antifungal activity against wood decay fungi.
2. Materials and Methods
2.1. Isolation of Endophytic Fungi
Endophytic fungi were isolated from wood tissue samples collected from both healthy and decayed P. yedoensis planted as urban street trees in Gyeongnam province in 2022~2023. The healthy and decayed trees were determined after measuring the internal defect rate at the lower part of the stem using a sonic tomograph. Wood tissue samples (100 wood drilling fragments) were collected from 5 healthy trees with a 0~1% defect rate and 5 decayed trees with a 35~45% defect rate using auger drilling. The samples were gently washed under tap water and then surface-sterilized using a 2% sodium hypochlorite (NaOCl) solution for 5 min. This was followed by immersion in 70% ethanol for 3 min, after which they were rinsed three times with sterile distilled water, each rinse lasting 15 s. Once the surface was sterilized, the samples were dried to prepare for the isolation of endophytic fungi. They were cut into small pieces measuring 5 × 5 × 8 mm using sterile tools and placed on Petri dishes containing Potato Dextrose Agar (PDA) with antibiotics (100 mg/L streptomycin). The agar plates were incubated at 25 °C for 7 to 10 days until mycelial growth emerged from the samples. To purify the endophytic fungi, mycelial growth tips or single spores were cultured onto new PDA plates. Subcultures were conducted multiple times until completely pure isolates were obtained. The pure isolates were then coded and stored in agar slants at 4 °C for further studies.
2.2. Identification of Endophytic Fungi
Endophytic fungi were classified based on morphological characteristics such as colony appearance, color, mycelial growth, and sporulation structures, using both the naked eye and a microscope (Nikon Eclipse Ci-L, Tokyo, Japan). Genomic DNA was extracted using the Quick-DNA Fungal/Bacterial Miniprep Kit (ZYMO RESEARCH, Tustin, CA, USA). Mycelia from representative endophytic fungi, identified based on their morphological characteristics, were used for DNA extraction. The internal transcribed spacer (ITS) region of the ribosomal DNA (rDNA) was then amplified by a polymerase chain reaction (PCR) using a T-100 thermocycler from Biorad, Hercules, CA, USA. To amplify the ITS region, a combination of primers ITS1F (5′-CTTGGTCATTTAGAGGAAGTAA-3′) and ITS4 (5′-TCCTCCGCTTATTGATATGC-3′) was utilized [32]. The PCR conditions involved an initial denaturation step at 95 °C for 3 min, followed by 40 cycles of denaturation at 95 °C for 30 s, annealing at 54 °C for 50 s, and extension at 72 °C for 1 min. A final extension was performed at 72 °C for 5 min, after which the samples were stabilized and stored at 4 °C. The presence or absence of the amplified PCR product was confirmed using electrophoresis on a 1.5% agarose gel. The PCR product was subsequently purified with a DNA purification kit (Exonuclease, Thermo Scientific, Waltham, MA, USA). Macrogen Co., Ltd. performed the base sequence analysis using an ABI 3730xl autosequencer (Applied Biosystems, Waltham, MA, USA). The resulting sequence was edited with Chromas version 2.6.2 and BioEdit version 7.2.5, and the edited sequence was then identified as a similar species through a Nucleotide BLAST search in the National Center for Biotechnology Information (NCBI) database (https://blast.ncbi.nlm.nih.gov/Blast.cgi, 21 January 2025).
2.3. Testing for Antifungal Activities of Isolated Endophytic Fungi
For the primary screening, 257 isolates were used to test for antifungal activities against three wood decay fungi which were isolated from P. yedoensis, namely Ganoderma gibbosum (OR570866), Trametes versicolor (MN294847), and Vanderbylia fraxinea (OQ612670.1). These wood decay fungi were subcultured from agar slants that had been stored at 4 °C. A cork borer was used to take out mycelial plugs from endophytic fungi and the test pathogens. Four different endophytic fungal isolates were cultured on a PDA plate, equidistant and near the periphery. A mycelial plug of each pathogen was placed on the center of the PDA plate. All plates were incubated in the dark at 25 °C for 7 days to inspect the antifungal activities of endophytic fungal isolates. Inhibition zones were measured as distances between the colonies of the test fungus and endophytic fungi. Eleven endophytic fungal isolates with an inhibition zone above 1.0 mm were selected for the secondary screening. Endophytic fungi and test pathogens were cultured on opposite sides of PDA Petri dishes; only test pathogens were cultured without endophytic fungi for the control treatment. The mycelial growth inhibition (MGI) of endophytic fungi against test pathogens was calculated using the following formula:
where C is the mycelial growth of the test pathogen in the control plate, and T is the mycelial growth of the test pathogen in the treated plate.
2.4. Antifungal Activities of Culture Filtrates from Selected Endophytic Fungi
Three endophytic fungal isolates with the highest inhibition rates against each pathogen were selected for the culture filtrate test. A total of five isolates were chosen for this test: BEN07, BEN36, BEN37, BEN48, and BEN97. Culture filtrates were prepared, and experiments were conducted following the method of a previous study [12]. The culture filtrates were mixed with PDA medium (1:1) and tested under both heated (autoclaved at 121 °C for 15 min) and unheated (not autoclaved) conditions. The inhibition rates were measured based on the mycelial growth of the test pathogens in both the treatments and controls, and these rates were calculated using the formula mentioned above.
BEN48 was selected to assess the effects of culture filtrate concentration on the mycelial growth of wood decay fungi. The culture filtrate of BEN48 was mixed with Potato Dextrose Agar (PDA) at three concentrations: 10%, 30%, and 50%. The assessment of antifungal activity at different concentrations was conducted in a manner similar to the previous experiment.
2.5. Statistical Analysis
A one-way analysis of variance (ANOVA) was conducted, followed by Tukey’s honestly significant difference (HSD) test as the post hoc analysis, to examine the differences in antifungal activities against wood decay fungi among endophytic fungal isolates at a 5% significance level. All statistical analyses were performed using IBM SPSS Statistics version 27 for Windows.
3. Results
3.1. Diversity of Endophytic Fungi Isolated from P. yedoensis
The diversity of endophytic fungi isolated from P. yedoensis is summarized in Table 1. A total of 257 endophytic fungal isolates were collected, with 184 sourced from decayed trees and 73 from healthy trees. In total, 49 species were identified from all isolates, comprising 16 species that were found exclusively in decayed trees, 18 species that were found exclusively in healthy trees, and 15 species that were present in both decayed and healthy trees (Figure 1). The frequency of Parapyrenochaeta maryellenpeartiae was the highest in decayed trees, occurring at a rate of 35.87%, compared to 21.92% in healthy trees. The second most frequent species in decayed trees was Paraboeremia putaminum, at 11.96%, followed by Paraconiothyrium brasiliense, which accounted for 9.24%. In healthy trees, the frequencies were similar for Paraconiothyrium brasiliense at 9.59% and Pyrenochaeta sp. at 8.22% (Table 1). Several fungal species were identified only once during the isolation process, with a frequency of occurrence of 0.54% in decayed trees and 1.37% in healthy trees such as Allophoma zantedeschiae, Aspergillus sydowii, Cladosporium perangustum, Cladosporium ramotenellum, and Nigrograna acericola (Table 1).

Table 1.
Diversity and frequency comparisons of endophytic fungi isolated from decayed and healthy P. yedoensis trees.

Figure 1.
Venn diagram illustrating number of endophytic fungal isolates overlapped and non-overlapped from decayed and healthy P. yedoensis trees.
3.2. Screening of Endophytic Fungi Against Wood Decay Fungi in Dual Culture Test
The evaluation results of endophytic fungal isolates with antifungal activity against wood-decaying fungi are presented in Table 2 and illustrated in Figure 2. Eleven isolates demonstrated antifungal activity against three wood decay fungi: Trametes versicolor (FP268), Ganoderma gibbosum (FP281), and Vanderbylia fraxinea (FP287). Among 11 antifungal isolates, only 1 was obtained from decay trees, while the others were sourced from healthy trees. The mycelial growth inhibition rates of the endophytic fungi against Trametes versicolor ranged from 12.59% to 40.27%. The inhibition rates against Ganoderma gibbosum ranged from 12.50% to 47.51%, while the rates against Vanderbylia fraxinea ranged from 28.49% to 62.16%.

Table 2.
Mycelial growth inhibition rate (%) of endophytic fungi isolates against wood decay fungi in dual culture assay.
Figure 2.
Antifungal activity of endophytic fungal isolates (left) against wood decay fungi (right) in dual culture assay. BEN07: Paraconiothyrium brasiliense; BEN36: Paraconiothyrium sp.; BEN37: Paraboeremia putaminum; BEN48: Fusarium acuminatum; BEN97: Nigrograna acericola.
The three isolates that exhibited the strongest inhibitory effects on Trametes versicolor were Paraconiothyrium sp. (BEN36), Fusarium acuminatum (BEN48), and Paraboeremia putaminum (BEN37), with inhibition rates of 40.27%, 35.05%, and 33.09%, respectively. For Ganoderma gibbosum, the isolates Nigrograna acericola (BEN97), Fusarium acuminatum (BEN48), and Paraconiothyrium sp. (BEN36) demonstrated the highest antifungal activity with inhibition rates of 47.51%, 42.96%, and 37.70%, respectively. When it comes to Vanderbylia fraxinea, Fusarium acuminatum (BEN48), Paraconiothyrium brasiliense (BEN07), and Paraconiothyrium sp. (BEN36) showed the highest inhibition rates of 62.16%, 59.06%, and 58.51%, respectively. These five isolates, BEN07, BEN36, BEN37, BEN48, and BEN97, were selected for the culture filtrate test.
3.3. Inhibitory Activity of Culture Filtrate Against Wood Decay Fungi
The culture filtrate of endophytic fungi displayed significant differences in antifungal activity against Trametes versicolor. Notably, isolate BEN48 exhibited the highest inhibition rate, with values of 80.5% under heated conditions and 83.5% under unheated conditions, showing no significant difference between the two (Figure 3). Isolate BEN37 had the second highest antifungal activity, with inhibition rates of 33.4% when heated and 38.8% when unheated. Isolate BEN07 was the only one that showed a significant difference between the heated and unheated conditions; however, its inhibition rates were lower than those of BEN48 and BEN37. Both BEN36 and BEN97 were almost entirely inactive against Trametes versicolor, with inhibition rates ranging from 2.2% to 3.7%.

Figure 3.
Antifungal activity of heated and unheated culture filtrates from endophytic fungal isolates against Trametes versicolor. Bars represent standard error of mean (n = 5). Bars labeled with same letter are not significantly different between temperature treatments at p < 0.05 using Tukey’s honestly significant difference test.
The isolate BEN48 showed the highest inhibition rate against Ganoderma gibbosum, with rates of 40.3% under heated conditions and 38.8% under unheated conditions. No significant difference was observed between these two conditions (Figure 4). In contrast, the culture filtrate from BEN07 displayed a significant difference in antifungal activity against Ganoderma gibbosum, exhibiting inhibition rates of 5.5% under heated conditions and 27.1% under unheated conditions. Meanwhile, isolates BEN37, BEN36, and BEN97 showed lower inhibition rates, with no significant difference between the heated and unheated conditions.

Figure 4.
Antifungal activity of heated and unheated culture filtrates from endophytic fungal isolates against Ganoderma gibbosum. Bars represent standard error of mean (n = 5). Bars labeled with same letter are not significantly different between temperature treatments at p < 0.05 using Tukey’s honestly significant difference test.
The evaluation of the antifungal capability of endophytic fungi against Vanderbylia fraxinea indicated that isolate BEN48 demonstrated the highest inhibition rates, achieving 72.4% under heated conditions and 76.1% under unheated conditions (Figure 5). Antifungal activity varied significantly among the different isolates. In the heated condition, some isolates, such as BEN07 and BEN37, exhibited significant differences in activity, while others showed no significant differences.

Figure 5.
Antifungal activity of heated and unheated culture filtrates from endophytic fungal isolates against Vanderbylia fraxinea. Bars represent standard error of mean (n = 5). Bars labeled with same letter are not significantly different between temperature treatments at p < 0.05 using Tukey’s honestly significant difference test.
3.4. Effects of Culture Filtrate Concentration of Endophytic Fungi on Antifungal Activity
The culture filtrate of the endophytic fungus Fusarium acuminatum (BEN48) was mixed with PDA medium at three different concentrations. The antifungal activity of this fungus against wood decay fungi is shown in Figure 6 and Figure 7. The antifungal activity at a concentration of 50% was greater than that at other concentrations for all three wood decay fungi. In general, the inhibition rates of Ganoderma gibbosum by BEN48 were lower than Trametes versicolor and Vanderbylia fraxinea at all concentrations. There was a significant difference among concentrations, and the inhibition rate significantly decreased as the concentration of the culture filtrate was reduced. In Trametes versicolor, the inhibition rate decreased from 96.5% at a 50% concentration to 83.7% at a 30% concentration and 50.8% at a 10% concentration. In Ganoderma gibbosum, the inhibition rate dropped from 64.1% at 50% concentration to 52.6% at 30% concentration and 24.5% at 10% concentration. For Vanderbylia fraxinea, there was a significant difference between the 50% concentration and the lower concentrations of 30% and 10%. However, no significant difference was observed between the 30% and 10% concentrations, and the inhibition rates for all three concentrations were high, measuring 92.7%, 89.9%, and 88.8%, respectively (Figure 6 and Figure 7).

Figure 6.
Antifungal activity of endophytic fungus Fusarium acuminatum (BEN48) against three wood decay fungi at different concentrations of culture filtrates. Bars labeled with same letter are not significantly different between temperature treatments at p < 0.05 using Tukey’s honestly significant difference test.
Figure 7.
Mycelial growth of wood decay fungi on PDA medium amended with different concentrations of culture filtrate from endophytic fungus Fusarium acuminatum (BEN48).
4. Discussion
Endophytic fungi isolated from P. yedoensis showed high abundance and diversity. A total of 33 species were identified from healthy trees, while 31 species were found in decayed trees (Table 1, Figure 1). The frequency of endophytic fungi differed between healthy and decayed trees. Among them, Parapyrenochaeta maryellenpeartiae had the highest frequency, followed by Paraboeremia putaminum and Paraconiothyrium brasiliense. These endophytic fungi, which were isolated from healthy trees, also had antifungal activities against wood decay fungi (Table 2). These fungi may contribute to the overall health of the trees without wood decay fungal infections. Endophytic fungal diversity was more abundant in Quercus serrata than in Quercus mongolica. The abundance of endophytic fungi with antifungal activity was higher in resistant trees compared to those susceptible to oak wilt disease [33]. Paraboeremia putaminum was also isolated from the roots of licorice plants (Glycyrrhiza uralensis), and its colonization could alter the fungal and bacterial communities in the rhizosphere of licorice plants [34,35]. Paraconiothyrium brasiliense is also an endophytic fungus obtained from the fruit of bell pepper (Capsicum annuum) and can produce flavonoids that have a wide range of antibacterial activity [36,37,38].
The culture filtrate from Fusarium acuminatum (BEN48) effectively inhibited the growth of Trametes versicolor, Ganoderma gibbosum, and Vanderbylia fraxinea. Interestingly, the antifungal activity of this culture filtrate remained unchanged under different heating conditions (Figure 3, Figure 4 and Figure 5). In contrast, the antifungal activities of certain endophytic fungi, such as Colletotrichum acutatum, Daldinia childiae, and Alternaria alternata, were influenced by heating conditions [12]. Additionally, culture filtrates from Streptomyces blastmyceticus demonstrated a significant difference in effectiveness between heated and unheated conditions when controlling oak wilt fungus [39]. Generally, the antifungal activities of culture filtrates tend to decrease under heated conditions compared to unheated conditions [12,39]. The concentration of the culture filtrate also affected its antifungal activity against wood decay fungi, and higher concentrations resulted in greater inhibition rates (Figure 6 and Figure 7). At a 50% concentration, the culture filtrate from Fusarium acuminatum (BEN48) exhibited the highest inhibition rates of 96.5%, 64.1%, and 92.7% against Trametes versicolor, Ganoderma gibbosum, and Vanderbylia fraxinea, respectively (Figure 6). When inhibiting Vanderbylia fraxinea, concentrations of 30% and 10% still demonstrated high inhibition rates of 89.9% and 88.8%, respectively (Figure 6).
Fusarium acuminatum is a fungal pathogen causing leaf spots in Saposhnikovia divaricata [40] and potato dry rot [41]. Other studies indicated that Fusarium acuminatum caused Fusarium head blight in cereal grains [42,43,44]. This fungus also caused postharvest rot on stored Kiwifruit [45] and root rot on Ophiopogon japonicus [46] and Astragalus membranaceus [47]. However, several studies have indicated that Fusarium acuminatum exhibits various biological activities [48,49]. For instance, two metabolic products, acuminatopyrone and chlamydosporol, have been extracted from this fungus [48]. Additionally, Fusarium acuminatum has the ability to uptake metals and produce antioxidant and lipid enzymes [49]. Our study demonstrates that the culture filtrate of the endophytic fungus Fusarium acuminatum (BEN48) can be used for the biological control of wood decay fungi such as Trametes versicolor, Ganoderma gibbosum, and Vanderbylia fraxinea. Additionally, heating has been found to not affect the antifungal activity of the culture filtrate. Therefore, the research and development of biological products and biological pesticides from potential raw materials of Fusarium acuminatum (BEN48) is necessary and should be carried out in further studies.
5. Conclusions
The diversity of endophytic fungi isolated from P. yedoensis varied between decayed and healthy trees. A total of 31 species were isolated from decayed trees, while 33 species were obtained from healthy trees. The healthy trees exhibited a greater abundance of endophytic fungi that were effective in mycelial inhibition against wood decay fungi compared to the decayed trees. The culture filtrate of Fusarium acuminatum (BEN48) demonstrated the highest inhibition rates against wood decay fungi, specifically Trametes versicolor, Ganoderma gibbosum, and Vanderbylia fraxinea. Additionally, heating did not affect the antifungal activity of the culture filtrate from BEN48. The concentration of this culture filtrate had significant effects on Trametes versicolor and Ganoderma gibbosum. In the case of Vanderbylia fraxinea, a significant difference was observed between the 50% concentration and the lower concentrations of 30% and 10%. Notably, the inhibition rates across all concentrations exceeded 88%. Therefore, Fusarium acuminatum (BEN48) shows potential for developing a biofungicide to control wood decay fungi and other plant pathogens.
Author Contributions
Conceptualization, N.K. and K.S.; methodology, M.K. (Misong Kim), M.H.N., S.L., N.K. and K.S.; software, M.K. (Misong Kim), M.H.N., S.L. and K.S.; validation, M.K. (Misong Kim), M.H.N., N.K. and K.S.; formal analysis, M.K. (Misong Kim) and M.H.N.; investigation, M.K. (Misong Kim), W.H., M.K., (Minyoung Kim) H.J. and J.L.; resources, W.H., M.K. (Minyoung Kim), H.J., J.L. and S.S.; data curation, M.K. (Misong Kim), M.H.N. and S.L.; writing—original draft preparation, M.K. (Misong Kim) and M.H.N.; writing—review and editing, N.K. and K.S.; supervision, N.K. and K.S. All authors have read and agreed to the published version of the manuscript.
Funding
This research was supported by the National Research Foundation of Korea (NRF) (No. RS-2023-00250589), the National Institute of Forest Science, Korea (Project No. FE0703-2023-02-2023), and the research grant of the Gyeongsang National University in 2022.
Institutional Review Board Statement
Not applicable.
Informed Consent Statement
Not applicable.
Data Availability Statement
The data presented in this study are available on request from the corresponding authors. The data are not publicly available due to institutional policy.
Conflicts of Interest
The authors declare no conflicts of interest.
References
- Pirttilä, A.M.; Frank, A.C. Endophytes of Forest Trees: Biology and Applications, 2nd ed.; Forestry Sciences; Springer International Publishing AG: Cham, Switzerland, 2018; ISBN 978-3-319-89832-2. [Google Scholar]
- Sun, X.; Guo, L.-D. Endophytic Fungal Diversity: Review of Traditional and Molecular Techniques. Mycology 2012, 3, 65–76. [Google Scholar] [CrossRef]
- Rashmi, M.; Kushveer, J.S.; Sarma, V.V. A Worldwide List of Endophytic Fungi with Notes on Ecology and Diversity. Mycosphere 2019, 10, 798–1079. [Google Scholar] [CrossRef]
- Aly, A.H.; Debbab, A.; Proksch, P. Fungal Endophytes: Unique Plant Inhabitants with Great Promises. Appl. Microbiol. Biotechnol. 2011, 90, 1829–1845. [Google Scholar] [CrossRef] [PubMed]
- Pirttilä, A.M.; Frank, A.C. (Eds.) Endophytes of Forest Trees: Biology and Applications; Forestry Sciences; Springer: Dordrecht, The Netherlands; New York, NY, USA, 2011; ISBN 978-94-007-1598-1. [Google Scholar]
- Jia, Q.; Qu, J.; Mu, H.; Sun, H.; Wu, C. Foliar Endophytic Fungi: Diversity in Species and Functions in Forest Ecosystems. Symbiosis 2020, 80, 103–132. [Google Scholar] [CrossRef]
- Arnold, A.E. Understanding the Diversity of Foliar Endophytic Fungi: Progress, Challenges, and Frontiers. Fungal Biol. Rev. 2007, 21, 51–66. [Google Scholar] [CrossRef]
- Gamboa, M.A.; Laureano, S.; Bayman, P. Measuring Diversity of Endophytic Fungi in Leaf Fragments: Does Size Matter? Mycopathologia 2003, 156, 41–45. [Google Scholar] [CrossRef]
- Stone, J.K.; Polishook, J.D.; White, J.F. Endophytic Fungi. In Biodiversity of Fungi; Elsevier: Amsterdam, The Netherlands, 2004; pp. 241–270. ISBN 978-0-12-509551-8. [Google Scholar]
- Posada, F.; Vega, F.E. Inoculation and Colonization of Coffee Seedlings (Coffea arabica L.) with the Fungal Entomopathogen Beauveria bassiana (Ascomycota: Hypocreales). Mycoscience 2006, 47, 284–289. [Google Scholar] [CrossRef]
- Nair, D.N.; Padmavathy, S. Impact of Endophytic Microorganisms on Plants, Environment and Humans. Sci. World J. 2014, 2014, 250693. [Google Scholar] [CrossRef]
- Nguyen, M.H.; Yong, J.H.; Sung, H.J.; Lee, J.K. Screening of Endophytic Fungal Isolates Against Raffaelea quercus-mongolicae Causing Oak Wilt Disease in Korea. Mycobiology 2020, 48, 484–494. [Google Scholar] [CrossRef]
- Nguyen, M.H.; Park, I.-K.; Lee, J.K.; Lee, D.-H.; Shin, K. Antifungal Activity of Culture Filtrate from Endophytic Fungus Nectria balsamea E282 and Its Fractions against Dryadomyces quercus-mongolicae. Forests 2024, 15, 332. [Google Scholar] [CrossRef]
- Masi, M.; Maddau, L.; Linaldeddu, B.T.; Scanu, B.; Evidente, A.; Cimmino, A. Bioactive Metabolites from Pathogenic and Endophytic Fungi of Forest Trees. Curr. Med. Chem. 2018, 25, 208–252. [Google Scholar] [CrossRef] [PubMed]
- Puri, S.K.; Habbu, P.V.; Kulkarni, P.V.; Kulkarni, V.H. Nitrogen Containing Secondary Metabolites from Endophytes of Medicinal Plants and Their Biological/Pharmacological Activities—A Review. Syst. Rev. Pharm. 2018, 9, 22–30. [Google Scholar] [CrossRef]
- Qin, J.-C.; Zhang, Y.-M.; Gao, J.-M.; Bai, M.-S.; Yang, S.-X.; Laatsch, H.; Zhang, A.-L. Bioactive Metabolites Produced by Chaetomium globosum, an Endophytic Fungus Isolated from Ginkgo Biloba. Bioorg. Med. Chem. Lett. 2009, 19, 1572–1574. [Google Scholar] [CrossRef] [PubMed]
- Omoto, Y.; Aono, Y. Effect of Urban Warming on Blooming of Prunus yedoensis. Energy Build. 1991, 15–16, 205–212. [Google Scholar] [CrossRef]
- Zhang, Y.Q.; Guan, L.; Zhong, Z.Y.; Chang, M.; Zhang, D.K.; Li, H.; Lai, W. The Anti-inflammatory Effect of Cherry Blossom Extract (Prunus Yedoensis) Used in Soothing Skincare Product. Int. J. Cosmet. Sci. 2014, 36, 527–530. [Google Scholar] [CrossRef]
- Kim, D.H. Practical Methods for Rapid Seed Germination from Seed Coat-Imposed Dormancy of Prunus yedoensis. Sci. Hortic. 2019, 243, 451–456. [Google Scholar] [CrossRef]
- Hwang, Y.; Kim, J.; Ryu, Y. Canopy Structural Changes Explain Reductions in Canopy-Level Solar Induced Chlorophyll Fluorescence in Prunus yedoensis Seedlings under a Drought Stress Condition. Remote Sens. Environ. 2023, 296, 113733. [Google Scholar] [CrossRef]
- Kim, C.; Kim, C.-S.; Mun, J.-H.; Kim, J.-H. Epitypification of Prunus × nudiflora (Rosaceae), a Natural Hybrid Species in Jeju Island, Korea. J. Asia-Pac. Biodivers. 2019, 12, 718–720. [Google Scholar] [CrossRef]
- Kim, C.-S.; Kim, Z.-S. Effects of Cutting Time, Auxin Treatment, and Cutting Position on Rooting of the Green-Wood Cuttings and Growth Characteristics of Transplanted Cuttings in the Adult Prunus yedoensis. Korean J. Hortic. Sci. Technol. 2012, 30, 129–136. [Google Scholar] [CrossRef]
- Cheong, E.J.; Na, M.; Jeong, U. The Effect of Endophytic Bacteria on in Vitro Shoot Growth of Prunus yedoensis and Its Identification and Elimination. In Vitro Cell. Dev. Biol.-Plant 2020, 56, 200–206. [Google Scholar] [CrossRef]
- Cheong, E.J.; Kim, C.S. Differentiation of Winter Buds of Prunus yedoensis Matsumura from Jeju Island Depending on the Collection Time and Media Conditions. J. Korean Soc. For. Sci. 2000, 89, 522–526. [Google Scholar]
- Velmurugan, P.; Cho, M.; Lim, S.-S.; Seo, S.-K.; Myung, H.; Bang, K.-S.; Sivakumar, S.; Cho, K.-M.; Oh, B.-T. Phytosynthesis of Silver Nanoparticles by Prunus yedoensis Leaf Extract and Their Antimicrobial Activity. Mater. Lett. 2015, 138, 272–275. [Google Scholar] [CrossRef]
- Velmurugan, P.; Sivakumar, S.; Song, Y.C.; Jang, S.H. Crystallization of Silver Metal by Extract of Prunus × yedoensis Matsumura Blossoms and Its Potential Characterization. J. Ind. Eng. Chem. 2015, 31, 39–42. [Google Scholar] [CrossRef]
- Manikandan, V.; Velmurugan, P.; Park, J.-H.; Lovanh, N.; Seo, S.-K.; Jayanthi, P.; Park, Y.-J.; Cho, M.; Oh, B.-T. Synthesis and Antimicrobial Activity of Palladium Nanoparticles from Prunus × yedoensis Leaf Extract. Mater. Lett. 2016, 185, 335–338. [Google Scholar] [CrossRef]
- Manikandan, V.; Velmurugan, P.; Hong, S.-C.; Yi, P.-I.; Jang, S.-H.; Suh, J.-M.; Jung, E.-S.; Russel, M.; Sivakumar, S. Novel Green Synthesis of a Reduced Graphene Oxide/Zinc Oxide Hybrid Nanocomposite Adsorbent of Prunus × yedoensis Leaf Extract: Its Catalytic Potential to Remove Phosphate. Desalination Water Treat. 2018, 130, 124–131. [Google Scholar] [CrossRef]
- Cho, S.-E.; Kang, H.; Lee, D.-H.; Seo, S.-T.; Kim, N.; Lee, S.; Kim, M.; Shin, K. The Complete Mitochondrial Genome of a Wood-Decaying Fungus Vanderbylia Fraxinea (Polyporaceae, Polyporales). Mitochondrial DNA Part B 2023, 8, 1187–1191. [Google Scholar] [CrossRef]
- Cho, S.-E.; Lee, S.-G.; Kim, M.-S.; Park, S.-H.; Park, J.-B.; Kim, N.-K.; Seo, S.-T.; Lee, D.-H.; Shin, K. First Report of Ganoderma gibbosum (Ganodermataceae, Basidiomycota), a Wood-Rotting Fungus of Urban Trees in Korea. J. Asia-Pac. Biodivers. 2024, 17, 228–231. [Google Scholar] [CrossRef]
- Jung, S.J.; Kim, N.K.; Lee, D.-H.; Hong, S.I.; Lee, J.K. Screening and Evaluation of Streptomyces Species as a Potential Biocontrol Agent against a Wood Decay Fungus, Gloeophyllum trabeum. Mycobiology 2018, 46, 138–146. [Google Scholar] [CrossRef]
- White, T.J.; Bruns, T.; Lee, S.; Taylor, J. Amplification and Direct Sequencing of Fungal Ribosomal RNA Genes for Phylogenetics. In PCR Protocols: A Guide to Methods and Applications; Elsevier: Amsterdam, The Netherlands, 1990; pp. 315–322. ISBN 978-0-12-372180-8. [Google Scholar]
- Nguyen, M.H.; Shin, K.C.; Lee, J.K. Fungal Community Analyses of Endophytic Fungi from Two Oak Species, Quercus mongolica and Quercus serrata, in Korea. Mycobiology 2021, 49, 385–395. [Google Scholar] [CrossRef]
- He, C.; Cui, J.; Chen, X.; Wang, W.; Hou, J. Effects of Enhancement of Liquorice Plants with Dark Septate Endophytes on the Root Growth, Glycyrrhizic Acid and Glycyrrhizin Accumulation Amended with Organic Residues. Curr. Plant Biol. 2020, 23, 100154. [Google Scholar] [CrossRef]
- He, C.; Zeng, Q.; Chen, Y.; Chen, C.; Wang, W.; Hou, J.; Li, X. Colonization by Dark Septate Endophytes Improves the Growth and Rhizosphere Soil Microbiome of Licorice Plants under Different Water Treatments. Appl. Soil. Ecol. 2021, 166, 103993. [Google Scholar] [CrossRef]
- Sathiyaseelan, A.; Saravanakumar, K.; Mariadoss, A.V.A.; Kim, K.M.; Wang, M.-H. Antibacterial Activity of Ethyl Acetate Extract of Endophytic Fungus (Paraconiothyrium Brasiliense) through Targeting Dihydropteroate Synthase (DHPS). Process Biochem. 2021, 111, 27–35. [Google Scholar] [CrossRef]
- Sathiyaseelan, A.; Saravanakumar, K.; Naveen, K.V.; Han, K.-S.; Zhang, X.; Jeong, M.S.; Wang, M.-H. Combination of Paraconiothyrium Brasiliense Fabricated Titanium Dioxide Nanoparticle and Antibiotics Enhanced Antibacterial and Antibiofilm Properties: A Toxicity Evaluation. Environ. Res. 2022, 212, 113237. [Google Scholar] [CrossRef] [PubMed]
- Taguchi, J.; Saito, T.; Yajima, A. Synthesis and Absolute Configuration of Paraconiothin I, a Structurally Unique Sesquiterpene Isolated from the Endophytic Fungus Paraconiothyrium brasiliense ECN258. Tetrahedron Lett. 2023, 131, 154789. [Google Scholar] [CrossRef]
- Hong, A.R.; Yun, J.H.; Yi, S.H.; Lee, J.H.; Seo, S.T.; Lee, J.K. Screening of Antifungal Microorganisms with Strong Biological Activity against Oak Wilt Fungus, Raffaelea quercus-mongolicae. J. For. Environ. Sci. 2018, 34, 395–404. [Google Scholar] [CrossRef]
- Jiang, Y.; Zhang, L.; Wang, S.; Li, Y.; Bai, Y.; Cao, L. Evaluation and Control of Fusarium acuminatum Causing Leaf Spot in Saposhnikovia Divaricata in Northeast China. Plant Dis. 2024, 108, 1139–1145. [Google Scholar] [CrossRef]
- Osawa, H.; Sakamoto, Y.; Akino, S.; Kondo, N. Autumn Potato Seedling Failure Due to Potato Dry Rot in Nagasaki Prefecture, Japan, Caused by Fusarium acuminatum and Fusarium commune. J. Gen. Plant Pathol. 2021, 87, 46–50. [Google Scholar] [CrossRef]
- Karlsson, I.; Persson, P.; Friberg, H. Fusarium Head Blight From a Microbiome Perspective. Front. Microbiol. 2021, 12, 628373. [Google Scholar] [CrossRef]
- Beccari, G.; Prodi, A.; Tini, F.; Bonciarelli, U.; Onofri, A.; Oueslati, S.; Limayma, M.; Covarelli, L. Changes in the Fusarium Head Blight Complex of Malting Barley in a Three-Year Field Experiment in Italy. Toxins 2017, 9, 120. [Google Scholar] [CrossRef]
- Becher, R.; Miedaner, T.; Wirsel, S.G.R. Biology, Diversity, and Management of FHB-Causing Fusarium Species in Small-Grain Cereals. In Agricultural Applications; Kempken, F., Ed.; Springer: Berlin/Heidelberg, Germany, 2013; pp. 199–241. ISBN 978-3-642-36820-2. [Google Scholar]
- Wang, C.W.; Ai, J.; Fan, S.T.; Lv, H.Y.; Qin, H.Y.; Yang, Y.M.; Liu, Y.X. Fusarium acuminatum: A New Pathogen Causing Postharvest Rot on Stored Kiwifruit in China. Plant Dis. 2015, 99, 1644. [Google Scholar] [CrossRef]
- Tang, T.; Wang, F.; Guo, J.; Guo, X.; Duan, Y.; You, J. Fusarium acuminatum Associated with Root Rot of Maidong (Ophiopogon japonicus) in China. Plant Dis. 2021, 105, 1860. [Google Scholar] [CrossRef] [PubMed]
- Wang, Y.; Wang, C.; Ma, Y.; Zhang, X.; Yang, H.; Li, G.; Li, X.; Wang, M.; Zhao, X.; Wang, J.; et al. Rapid and Specific Detection of Fusarium acuminatum and Fusarium solani Associated with Root Rot on Astragalus membranaceus Using Loop-Mediated Isothermal Amplification (LAMP). Eur. J. Plant Pathol. 2022, 163, 305–320. [Google Scholar] [CrossRef]
- Grove, J.F.; Hitchcock, P.B. Metabolic Products of Fusarium acuminatum: Acuminatopyrone and Chlamydosporol. J. Chem. Soc. Perkin Trans. 1 1991, 5, 997–999. [Google Scholar] [CrossRef]
- Kayali, H.A.; Tarhan, L. Variations in Metal Uptake, Antioxidant Enzyme Response and Membrane Lipid Peroxidation Level in Fusarium equiseti and F. acuminatum. Process Biochem. 2005, 40, 1783–1790. [Google Scholar] [CrossRef]
Disclaimer/Publisher’s Note: The statements, opinions and data contained in all publications are solely those of the individual author(s) and contributor(s) and not of MDPI and/or the editor(s). MDPI and/or the editor(s) disclaim responsibility for any injury to people or property resulting from any ideas, methods, instructions or products referred to in the content. |
© 2025 by the authors. Licensee MDPI, Basel, Switzerland. This article is an open access article distributed under the terms and conditions of the Creative Commons Attribution (CC BY) license (https://creativecommons.org/licenses/by/4.0/).